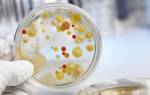

У 20% населения причиной насморка становится аллергия. Патология часто встречается у детей 3–6 лет, но может затронуть и взрослого. Насморк при аллергии – это реакция организма на раздражитель, который вызывает воспаление слизистой. Симптомы появляются сразу после контакта с ним: пыльцой, шерстью животного и пр. Патология не заразна и не угрожает жизни, но без лечения затяжной ринит может привести к астме.
Виды заболевания
По характеру течения аллергический насморк у взрослых делят на 3 типа:
- Эпизодический.Симптомы появляются при случайном контакте с аллергеном и проходят без лечения сами. Основные причины: шерсть животных, бытовая пыль, насекомые, продукты питания.
- Сезонный.Сильные приступы возникают на несколько часов сразу после контакта с раздражителем. Часто это связано с цветением растений и происходит в мае, июне и сентябре. Другое название патологии – сенная лихорадка.
- Круглогодичный.Симптомы аллергии появляются постоянно, приступы длятся несколько дней, но выражены слабо. Основные причины: бытовая пыль, химические вещества, насекомые.

У заболевания есть 3 степени тяжести:
- Легкая.Ринит постоянный, но слабый, общее состояние больного нормальное.
- Умеренная.Активность днем снижается, сон периодически нарушается.
- Тяжелая.Сон становится прерывистым, страдает нервная система. Человек не может работать, становится вялым.
Мнение врачей:
Лечение аллергического ринита у взрослых требует комплексного подхода. Врачи часто рекомендуют применение антигистаминных препаратов, таких как лоратадин, цетиризин или фексофенадин, для снижения симптомов аллергии. Эти препараты блокируют действие гистамина, уменьшая зуд, насморк и чихание. Кортикостероидные спреи, такие как флутиказон или бекклометазон, помогают снизить воспаление и отечность слизистой оболочки носа. Для тяжелых случаев аллергического ринита могут быть назначены дополнительные препараты, включая десенсибилизирующие средства или даже иммунотерапию. Важно проконсультироваться с врачом для выбора наиболее эффективного и безопасного лечения.

Симптомы
Важные признаки аллергического ринита – температуры нет или она ниже 37,5 градусов, а выделения из носа прозрачные и жидкие. У взрослых симптомы менее выражены, чем у детей.
Общее состояние больного зависит от степени тяжести патологии: при легкой человек ведет привычную жизнь, беспокоит его только насморк.
При средней – появляются другие симптомы:
- заложенность носа;
- сопение;
- зуд и жжение слизистой;
- гнусавость голоса;
- снижение обоняния;
- приступы чихания.

При затяжном аллергическом рините без лечения возникают дополнительные признаки патологии:
- Частые носовые кровотечения.
- Боли в горле, першение, легкий кашель – слизь стекает по задней стенке.
- Раздражение кожи у крыльев носа, при котором она краснеет и отекает.
- Боль в ушах, снижение слуха.
Если течение аллергического насморка у взрослых тяжелое, появляются симптомы общего недомогания:
- головные боли;
- раздражительность;
- плохой сон;
- снижение работоспособности, концентрации;
- вялость.
Что делать при аллергическом насморке
Лечение этой патологии комплексное: врач назначает пациенту лекарства и процедуры, дает рекомендации по образу жизни. Ключевой момент – ограничение контакта с аллергеном.
У взрослых причина ринита часто известна, поскольку первые симптомы появляются еще в детстве.
Если человек не знает свой аллерген, его выявляют при помощи кожных проб или анализа крови. Виды раздражителей и рекомендации:
- Пыльца растений.Избегайте парков и скверов в период цветения, по возможности выезжайте к морю на это время.
- Грибки.Избегайте контакта со скошенной травой, опавшими листьями, сырыми помещениями. Обработайте стены в ванной комнате, где часто скапливается плесень.
- Шерсть животных.Часто аллергическую реакцию вызывает белок кошачьей шерсти, поэтому попробуйте взять питомца другой породы или другого вида. В редких случаях придется совсем отказаться от контакта с животными.
- Общее:избегайте резких запахов – парфюмерии, бытовой химии (краски, стиральные порошки), табачного дыма.

При лечении аллергического насморка измените питание. Часто возникает перекрестная реакция между пищей и другим раздражителем: пыльцой, грибками. Многие продукты усиливают аллергию из-за большого количества гистамина – вещества, которое влияет на развитие воспаления. Рекомендации по питанию:
- Уберите из меню орехи, семечки, фрукты и ягоды красного цвета, мед – эти продукты усиливают любую аллергическую реакцию.
- При рините с апреля по середину мая забудьте про картофель, томаты, маслины, сельдерей. Из фруктов запрещены яблоки, груши, персики, киви, абрикосы, сливы.
- При рините в мае-июне откажитесь от ржаного и белого хлеба, макарон, каш: манной, овсяной, пшенной, рисовой. Запрещены квас, водка, пиво.
- При насморке с середины лета до октября откажитесь от халвы, семечек, подсолнечного масла, шпината, огурцов, кабачков, арбузов, горчицы, капусты.
- При аллергической реакции на грибки уберите из меню сыр с плесенью, сметану, сухофрукты, кефир, квашеную капусту, виноград. Откажитесь от пива, шампанского, кваса.
Важный этап лечения – создание комфортного воздуха:
- Проветривайте помещение каждый вечер. Для защиты от городской пыли, пыльцы и насекомых наденьте на окно марлю и регулярно протирайте ее влажной тряпкой.
- Используйте увлажнитель воздуха и очиститель со специальными фильтрами.
- Уберите тяжелые шторы, ковры, мягкие игрушки. Книжные полки держите закрытыми.
- 2 раза в неделю делайте влажную уборку дома.

Опыт других людей
Лечение аллергического ринита у взрослых может быть эффективным благодаря современным препаратам. Многие люди отмечают, что антигистаминные средства, такие как Лоратадин или Цетиризин, помогают справиться с симптомами аллергии, такими как насморк, зуд и чихание. Кортикостероидные спреи, например, Флутиказон или Беклометазон, также пользуются популярностью из-за своей эффективности в уменьшении воспаления и отека слизистой оболочки носа. Некоторые также отмечают положительный эффект от применения дезенсибилизирующих препаратов, которые помогают ослабить реакцию организма на аллергены. Важно помнить, что выбор препарата и его дозировка должны определяться врачом, исходя из индивидуальных особенностей пациента.
Схема лечения
При легком течении патологии взрослым выписывают антигистаминные препараты (таблетки, сироп) и капли в нос, которые сужают сосуды и облегчают дыхание. Местное лечение длится 3–5 дней. В схему терапии аллергического насморка у взрослого с умеренным или тяжелым течением включают гормональные препараты и сорбенты.
Если через месяц симптомы острой стадии не исчезли или ринит постоянный, повышают дозу гормональных средств.
Дополнительно назначают процедуры очищения крови и десенсибилизации – у больного вырабатывают устойчивость к аллергену.
Антигистаминные препараты

Такие лекарства работают как блокаторы рецепторов вещества, которое стимулирует развитие воспаления. Они уменьшают количество выделений из носа, облегчают дыхание, снимают отек, зуд. При легком течении патологии антигистаминные препараты – основа лечения, в остальных случаях это часть комплексной терапии.
Таблетки дают эффект уже через 20–30 минут после приема, работают в течение суток.
Антигистаминные лекарства делятся на 3 группы:
- 1 поколение: Тавегил, Димедрол, Диазолин.Обладают сильным снотворным эффектом, поэтому их назначают редко.
- 2 поколение: Лоратадин, Зиртек.Имеют слабый седативный (успокаивают) эффект, могут вызывать сонливость, тошноту, головную боль, сухость во рту.
- 3 поколение: Эриус, Супрастинекс.Начинают работать уже через 15 минут, более эффективны.
Сосудосуживающие капли

Эти средства снимают отек, уменьшают количество выделений из носа и облегчают дыхание. Они работают почти моментально, но только 4–8 часов. Такие препараты при аллергическом рините нельзя использовать дольше 5 дней, потому что они сушат слизистую, усиливают зуд и вызывают привыкание. Хорошие капли для взрослых: Тизин, Санорин, Виброцил. Последний препарат можно использовать 7 дней: в нем есть компонент, который уменьшает аллергическую реакцию.
Статьи по теме
- Гиперпластический ринит у взрослых и детей
- Холодовой ринит: как проявляется, причины заболевания слизистой носа
- Симптомы и лечение хронического ринита у ребенка и взрослого
Спреи от аллергического ринита
Беременным врачи советуют Превалин на натуральных компонентах (кунжутное и мятное масла), которые блокируют действие раздражителей. После впрыскивания спрей образует пленку на слизистой и предотвращает контакт с аллергеном. Симптомы патологии Превалин снимает слабо, эффект длится до 6 часов. Другие спреи от аллергического ринита:
- Стабилизаторы мембран тучных клеток, или кромоны.Спреи КромоГексал, Вивидрин предупреждают аллергическую реакцию. Их применяют при постоянном рините с легким или умеренным течением, результат появляется через неделю. На раннем сроке беременности такие препараты запрещены.
- М-холиноблокаторы.В этой группе как лекарство от аллергического ринита с хроническим течением применяют только Атровент. Он снижает выработку слизи, снимает заложенность носа.
Гормональная терапия
Капли и спреи на глюкокортикоидах Фликсоназе, Бенаринприменяют для лечения тяжелого ринита у взрослых. Они снимают воспаление и аллергическую реакцию, не дают болезни развиваться. Эффект виден через 1–3 недели лечения. Препараты работают местно, но в высоких дозах могут попасть в кровь. Это негативно влияет на иммунитет и обменные процессы, поэтому их используют строго по схеме врача.
Для отмены лекарства мягко снижают дозу: резко прекращать лечение запрещено.
Промывание носа
Процедура восстанавливает дыхание, снимает заложенность, увлажняет. Если раздражитель попал на слизистую, промывание уберет его и этим уменьшит симптомы патологии. Обязательно проводите процедуру, прежде чем использовать спрей или капли от аллергического ринита: это повысит эффект лечения. Противопоказаний к процедуре нет, срок терапии не ограничен. Удобнее всего промывать нос специальными спреями:
- АкваМарис, АкваЛор, РиноНорм– простые препараты на морской воде.
- Долфин– имеет в составе экстракты шиповника, корня солодки, поэтому смягчает слизистую, убивает патогенные бактерии.
Энтеросорбенты
При долгом контакте с раздражителем в организме появляются иммунные комплексы, от количества которых зависит сила аллергической реакции. Чтобы от них избавиться, применяют сорбенты – эти препараты связывают и выводят токсины и другие опасные соединения. Лечение аллергического насморка проводят 2 недели, в это время возможны запоры.
Сорбенты принимают отдельно от системных средств, соблюдая интервал в 2–3 часа.
Лучшие средства этой группы для взрослых:
- Полисорб;
- Энтеросгель;
- Смекта;
- Антрален;
- Карболен.
Гипосенсибилизация
Процедуру назначают взрослым, когда известен точный раздражитель и остальные методы лечения эффекта не дают. Проводят ее в стационаре. Больному делают инъекции с аллергеном, начиная с низких доз и постепенно увеличивая. Сначала процедуру проводят раз в 7 дней, после – с интервалом в 6 недель на протяжении 2–5 лет. Лечение помогает выработать устойчивость к аллергену, поэтому исключает новые приступы патологии. Противопоказания:
- бронхиальная астма;
- болезни сердца и сосудов.
Плазмаферез
Во время процедуры у больного забирают часть крови из вены, очищают от токсичных веществ и возвращают обратно. Выводятся аллергены, патологический процесс не развивается, поэтому состояние больного улучшается. Курс лечения – 3–5 процедур. Эффект сохраняется до года, если человек не контактирует с аллергеном. Показания к плазмаферезу:
- тяжелое течение аллергического насморка;
- круглогодичный ринит;
- конъюнктивит, астма;
- нельзя исключить контакты с раздражителем.
Народное лечение аллергического ринита
Многие рецепты основаны на травах и продуктах пчеловодства. Эти компоненты – сильные аллергены и могут только ухудшить состояние больного. Из народных средств относительно безопасен только раствор морской соли (1 ч. л. на 200 мл теплой воды), которым промывают нос с помощью груши или шприца. Это простая бюджетная замена аптечным спреям АкваЛор, АкваМарис. Другие народные рецепты использовать не стоит, особенно когда аллерген неизвестен.
Видео
Внимание!
Информация, представленная в статье, носит ознакомительный характер. Материалы статьи не призывают к самостоятельному лечению. Только квалифицированный врач может поставить диагноз и дать рекомендации по лечению, исходя из индивидуальных особенностей конкретного пациента.
Статья обновлена: 05.03.2019
Частые вопросы
Что лучше всего помогает от аллергического ринита?
Назальные спреи с кортикостероидами – наиболее эффективное лечение аллергического ринита. Они работают лучше всего при непрерывном использовании, но также могут быть полезны при использовании в течение более коротких периодов времени.
Какой антигистаминный препарат лучше при аллергическом рините?
Важно подобрать лекарство, которое будет работать именно в вашем случае. Например, для облегчения проявлений аллергического ринита, конъюнктивита рекомендуется использовать современные антигистаминные препараты второго поколения (цетиризин, дезлоратадин и др.).
Какие капли лучше при аллергическом рините?
Аллергический ринит и сосудосуживающие капли В популярных сосудосуживающих каплях содержаться нафазолин, ксилометазолин, оксиметазолин. Это их основные действующие вещества. Они эффективно устраняют выделения из носа, отек и воспаление, но использовать их надо только очень ограниченное время. Обычно не более 5-7 дней.
Какой спрей помогает от аллергического ринита?
«СаноринАналергин», «ТизинАлерджи», «Гистамет» – эти капли и спреи помогают снять симптомы аллергического насморка быстро, их можно использовать в течение достаточно долгого срока.
Полезные советы
СОВЕТ №1
Перед началом лечения аллергического ринита у взрослых обязательно проконсультируйтесь с врачом-аллергологом или отоларингологом для правильного диагноза и подбора эффективного препарата.
СОВЕТ №2
Избегайте самолечения и подбора препаратов наугад, так как это может ухудшить ситуацию и привести к нежелательным побочным эффектам.
СОВЕТ №3
Помимо лекарственных препаратов, обратите внимание на возможные аллергены в окружающей среде и попробуйте минимизировать контакт с ними (пыль, пух, пыльца растений и т.д.).